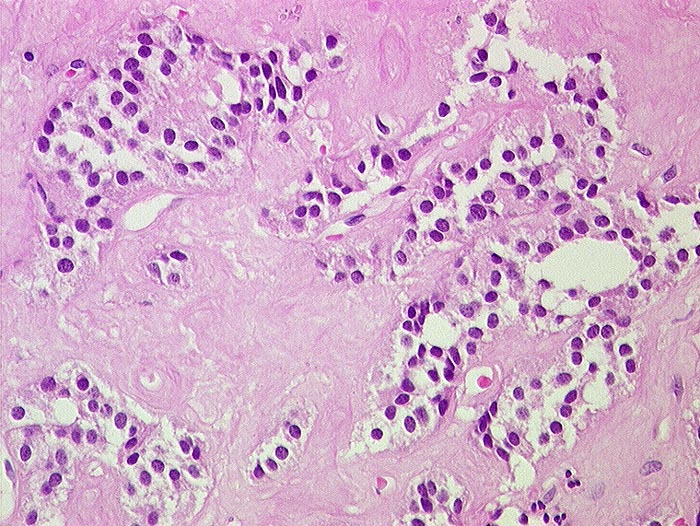

PathoPic – image database / PathoPic ID 1498 - Insulinom mit Amyloidstroma
de
Diagnose
Insulinom mit Amyloidstroma
Diagnose Gruppe
Präneoplasie/ Atypie/ Dignität?
Topographie
Pankreas
Topographie Gruppe
Leber, Gallenwege, Pankreas
Beschreibung
Reichlich fibrovaskuläres Stroma zwischen den Tumorzellen. Das amorphe Stroma enthält Amyloid. Die Tumorzellen sind auffallend monomorph, haben kleine runde Kerne mit Pfeffer-und-Salz Chromatin.
Kommentar
Amyloid kommt in den Insulinomen häufiger vor als bei anderen endokrinen Tumoren.
Bilder Typ
Histologie
Alter
42
Geschlecht
männlich
Datum
Ersteintrag: 10.12.2001
Update: 04.02.2024